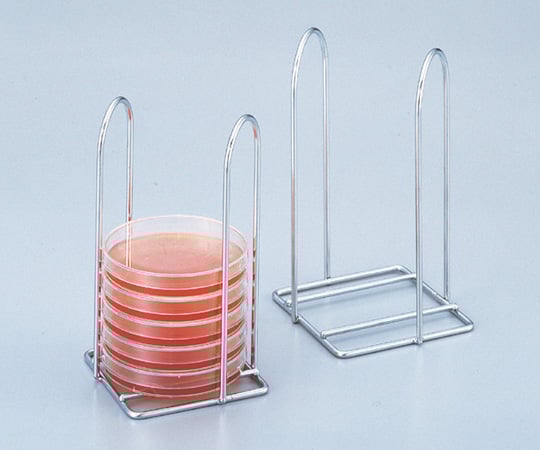
Petri dish stand φ75 suspension 6 pieces storage 1 piece

1
/
of
2
アズワン
Petri dish stand φ75 suspension 6 pieces storage 1 piece
Petri dish stand φ75 suspension 6 pieces storage 1 piece
Regular price
¥2,387
Regular price
Sale price
¥2,387
Unit price
/
per
Shipping calculated at checkout.
Couldn't load pickup availability
The petri dish containing the sample can be placed directly into the incubator. Material: Stainless steel (SUS304)
Storage capacity: φ75mm
Storage capacity: 6 sheets
Autoclavable
φ75 suspension
Size (mm): 92 x 92 x 165
RoHS2 (EU)2015/863 compliant [About RoHS]
View full details